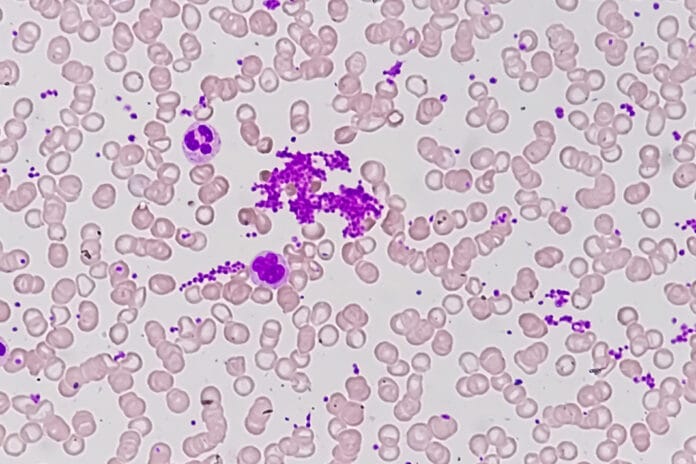
Macrothrombocytopenia

As dental hygienists, we encounter bleeding and inflamed gingiva daily. Most of the time, it is due to poor oral hygiene and a lack of disrupting that pesky biofilm. However, sometimes persistent bleeding gingiva can be a sign of something more serious. A plethora of systemic diseases can cause bleeding and inflammation of the gingival tissue, including macrothrombocytopenia, a group of rare disorders with the common feature of abnormally large platelets.
Recently, I was faced with trying to understand these conditions better as a dear friend’s son was diagnosed with a form of macrothrombocytopenia, and she was inquiring about oral manifestations and any details she should know to help her son’s dental team manage his care. It occurred to me that this may be a good topic for all dental professionals to better understand, which led to the writing of this article.
Etiology of Macrothrombocytopenia
Macrothrombocytopenia is a phenomenon of reduced platelet count with a significant increase in platelet size. The condition can be inherited or acquired. Macrothrombocytopenia can be acquired through a variety of clinical disorders, including infections, autoimmune diseases, bone marrow dysplasia, and in patients on certain chemotherapy drugs or radiation therapy.1,2
Multiple variations of inherited macrothrombocytopenia are classified into four groups based on structural defects, distinctive morphological findings, clinical associations with clinical manifestations, and benign anomalies.3
Classifications of inherited giant cell platelet disorders include:3
- With structural defects
- Glycoprotein abnormalities
- Bernard-Soulier syndrome
- Velocardiofacial syndrome
- Association with mitral valve defect
- Glycoprotein IV abnormalities
- Calpain defect
- Montreal platelet syndrome
- Alpha granules
- Gray platelet syndrome
- With abnormal neutrophil inclusion
- May-Hegglin anomaly
- Sebastian syndrome
- With systemic manifestations
- Hereditary macrothrombocytopenia with hearing loss
- Epstein syndrome
- Fechtner syndrome
- With no specific abnormalities
- Mediterranean macrothrombocytopenia
- Glycoprotein abnormalities
Epidemiology of Macrothrombocytopenia
Inherited platelet disorders are considered rare, with a prevalence of one in 10,000 to 1,000,000 persons worldwide.4 Though inherited platelet disorders affect both sexes equally, women are more likely to be diagnosed due to more occasions to experience bleeding challenges such as menstruation, childbirth, and endometrial hyperplasia.5
Though women tend to be diagnosed more frequently, men are still affected at a similar rate. This is important to understand because you may have a male patient who presents with clinical signs of a platelet disorder that has not been diagnosed.6
The same is true for varying age groups. Inherited platelet disorders are present from birth yet are often not diagnosed until later in life. One study suggested the mean age for diagnosis is 35 years of age.6
Oral Manifestations and Clinical Considerations
Oral manifestations may vary depending on platelet count. Thrombocytopenia, an aspect of macrothrombocytopenia, is classified into mild, moderate, severe, and life-threatening based on platelet count (see Figure 1). Unfortunately, there is no clear correlation between clinical signs and symptoms and platelet count.7
| Platelet Count
x 103/mm3 |
Severity | Oral Manifestations |
| 100-150 | Mild | Normal mucosa, sometimes slight increase in postoperative bleeding |
| 50-100 | Moderate | Postoperative bleeding, possible petechia, and ecchymosis |
| 30-50 | Severe | Sometimes spontaneous bleeding, multiple petechial, hemorrhage, ecchymosis, and blood blisters |
| <30 | Life-threatening | Spontaneous bleeding |
Figure 1 Low platelet count in relation to oral manifestations
Adapted from Khammissa, R.A.G., et al.7
Nonetheless, when patients have signs and symptoms, gingival bleeding is the most common oral manifestation. Gingival bleeding can be spontaneous but may also require some gingival manipulation to elicit the bleeding. Gingival bleeding may also continue longer than is normal due to the lack of platelets and the inability of the blood to properly coagulate.7
Depending on the severity of thrombocytopenia, patients may also present with thrombocytopenic purpura. Thrombocytopenia purpura manifests in multiple ways, including small petechial hemorrhages, ecchymosis (bruising), or spontaneous bleeding (see Image 1).7

Image courtesy Mdscottis
(CC BY-SA 3.0 via Wikimedia Commons)
When patients lack clinical signs and symptoms, it can make it difficult to determine if there is an increased risk of complications with dental treatment. These patients may not be aware they have a low platelet count; therefore, patients with a diagnosis of macrothrombocytopenia or any form of thrombocytopenia should get a platelet count before any extensive dental treatment that may cause bleeding. Patients without a diagnosis are a different concern as there is little that can be done to prevent excessive bleeding in these cases.7
Conclusion
Though macrothrombocytopenia is considered rare, it is still important to understand the signs, symptoms, and oral manifestations as, in some cases, excessive bleeding may require medical intervention. Additionally, many people are not diagnosed until adulthood; therefore, patients with excessive bleeding with no clear etiology may need to follow up with their medical provider.
If you have a patient who bleeds excessively and there is no improvement after oral hygiene interventions, consider referring the patient for bloodwork with their primary care physician. There are multiple systemic conditions that can manifest as gingival inflammation and bleeding, including macrothrombocytopenia, leukemia, and undiagnosed diabetes, among others.
Dental hygienists play an important role in managing oral and systemic conditions; this often includes collaboration with medical professionals. It is difficult to improve oral health if the patient has undiagnosed systemic conditions.
Moving forward, I hope all dental professionals work to collaborate with medical professionals to improve patients’ overall health. Bridging the gap between dentistry and medicine has been a process; however, dental professionals must continue to blaze the trail with the primary goal of improving patients’ health and quality of life.
Before you leave, check out the Today’s RDH self-study CE courses. All courses are peer-reviewed and non-sponsored to focus solely on high-quality education. Click here now.
Listen to the Today’s RDH Dental Hygiene Podcast Below:
References
- Kakkar, N., John, M.J., Mathew, A. Macrothrombocytopenia in North India: Role of Automated Platelet Data in the Detection of an Under Diagnosed Entity. Indian Journal of Hematology and Blood Transfusion. 2015; 31(1): 61-67. https://doi.org/10.1007/s12288-014-0367-3
- Ghosh, K., Bhattacharya, M., Chowdhury, R., et al. Inherited Macrothrombocytopenia: Correlating Morphology, Epidemiology, Molecular Pathology and Clinical Features. Indian Journal of Hematology and Blood Transfusion. 2018; 34(3): 387-397. https://doi.org/10.1007/s12288-018-0950-0
- Mhawech, P., Saleem, A. Inherited Giant Platelet Disorders: Classification and Literature Review. Am J Clin Pathol. 2000; 113(2): 176-190. https://academic.oup.com/ajcp/article/113/2/176/1757700
- Kim, B. Diagnostic Workup of Inherited Platelet Disorders. Blood Research. 2022; 57(S1): S11-S19. https://doi.org/10.5045/br.2022.2021223
- Gresele, P., Falcinelli, E., Bury, L. Inherited Platelet Disorders in Women. Thrombosis Research. 2019; 181(Suppl 1): S54-S59. https://doi.org/10.1016/S0049-3848(19)30368-8
- Sánchez-Guiu, I., Antón, A.I., Padilla, J., et al. Functional and Molecular Characterization of Inherited Platelet Disorders in the Iberian Peninsula: Results From a Collaborative Study. Orphanet Journal of Rare Diseases. 2014; 9: 213. https://doi.org/10.1186/s13023-014-0213-6
- Khammissa, R.A.G., Fourie, J., Masilana, A., et al. Oral Manifestations of Thrombocytopaenia. The Saudi Dental Journal. 2018; 30(1): 19-25. https://doi.org/10.1016/j.sdentj.2017.08.004